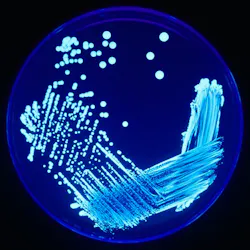
Legionella Plate 01 5ed8100e9c81e Legionella Plate 01 5ed8100e9c81e

ASHRAE publishes updated Legionella guideline
ATLANTA, GA — ASHRAE has published an updated guideline to assist in control of legionellosis associated with building water systems.
ASHRAE Guideline 12-2020, Managing the Risk of Legionellosis Associated with Building Water Systems, provides guidance useful in the implementation of ANSI/ASHRAE Standard 188, Legionellosis: Risk Management for Building Water Systems. The guideline is intended for use by owners of human-occupied buildings and those involved in the design, construction, installation, commissioning, management, operation, maintenance, and service of centralized building water systems and components.
“ASHRAE Standard 188 gives direction regarding what to do to control the spread of legionellosis, such as to follow a risk management process, but does not necessarily explain how to do it in a prescriptive way” says Paul Lindahl, committee chair for ASHRAE Standing Standard Project Committee (SSPC) 188, the committee responsible for writing Guideline 12-2020. “Guideline 12 complements Standard 188 by providing detailed guidance for water management program teams to develop the necessary elements of an effective water management plan. This can be a particularly important aspect of plans to reopen buildings following the COVID-19 pandemic.”
Guideline 12 applies to spaces such as hotels, office buildings, hospitals and other health care facilities, assisted living facilities, schools, universities, commercial buildings, industrial buildings and centralized systems in multifamily residential buildings. Buildings with noncentralized water systems, and single-family residential buildings, though not included, may also benefit.
Three presentations on Guideline 12-2020 will take place during the 2020 ASHRAE Virtual Conference.
- History of Standard 188, Guideline 12 and Other Guidelines
- ASHRAE Guideline 12 and the Facts about Legionella Growth in Building Water Systems
- Guideline 12 Is a Tool Designed to Support the Preparation of a Water Management Plan Using ANSI/ASHRAE Standard 188
While Legionnaire’s Disease has been known for many years, recent outbreaks have increased awareness of the disease, its causes, and prevention strategies. According to the World Health Organization, because many countries lack appropriate methods of diagnosing the infection or sufficient surveillance systems, the rate of occurrence is unknown.
Purchase ASHRAE Guideline 12-2020, Managing the Risk of Legionellosis Associated with Building Water Systems from the ASHRAE Bookstore or contact ASHRAE Customer by phone at 1-800-527-4723 (United States and Canada), 404-636-8400 (worldwide) or fax 678-539-2129.
About ASHRAE
Founded in 1894, ASHRAE is a global professional society committed to serve humanity by advancing the arts and sciences of heating ventilation, air conditioning, refrigeration and their allied fields. For more information and to stay up-to-date on ASHRAE, visit ashrae.org
Click here for Water Technology's ongoing coverage of COVID-19